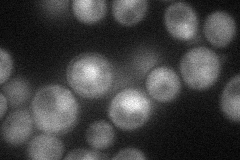
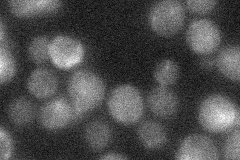

View description
B-type cyclin involved in cell cycle progression; activates Cdc28p to promote the G2/M transition; may be involved in DNA replication and spindle assembly; accumulates during S phase and G2, then targeted for ubiquitin-mediated degradation
Localization:
Intensity:
Fold change:
Significance:
-
C’ GFP library in SD

nucleus22.63 -
N' NOP1pr-GFP in SD
cytosol,nucleus35.2327 -
N' TEF2pr-mCherry in SD

missing0 -
N' NATIVEpr-GFP in SD
below threshold25.8844 -
N' TEF2pr-VC and Cyto-VN in SD

#N/A0 -
C’ GFP library in SD+DTT

nucleus21.350.94No -
C’ GFP library in SD+H2O2

nucleus20.240.89No -
C’ GFP library in Starvation Media

nucleus15.590.68Yes -
C’ GFP library on the background of Pup2-DaMP

nucleus -
C’ GFP library on the background of CCT mutant

nucleus23.83031.05245No
